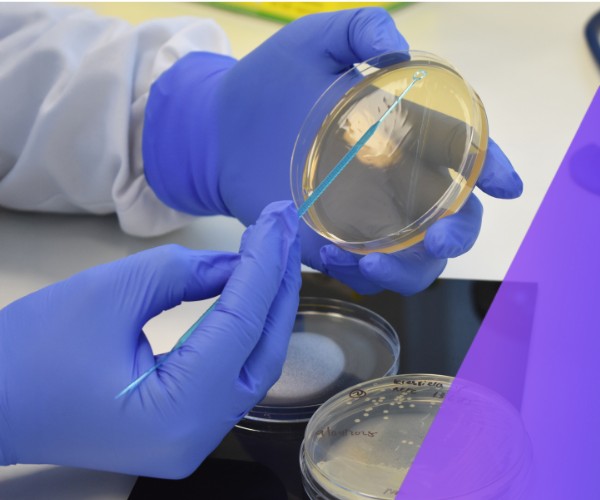

Virologica Testing Services
Virologica’s goal is to provide a quality, expert testing service that enables and supports product enhancement for our clients
Our Purpose Built Facility Houses Laboratories for Microbiology, Virology and Cell Biology
We offer a range of testing services including standard and customised methods. We work with our clients to understand their needs and we have the experience and expertise to devise the most appropriate test methods to demonstrate their products capabilities.
Virology
Specialised in viral testing for development or submission
In response to the COVID-19 pandemic, there is an increasing number and range of antiviral products in development and on the market. Assessing the performance and resistance of materials to viral contamination and the virucidal efficacy of disinfectants has never been more important.
Virology methods
ISO 21702, EN 14476, Viral inactivation/viral clearance, EN 16777, ISO 18184

Microbiology
Our experienced microbiology team can offer expertise and solutions to your problems
A huge range of products are developed with an antimicrobial claim, from medical devices to cleaning products to textiles. Virologica offers a range of standard and customised methods to take you through the development of products, to regulatory approval and marketing material.
Microbiology methods
Modified AATCC test method 100, ISO 22196, ISO 20776 (MIC), ASTM D7907, ASTM 3383
Biocompatibility
Working alongside our customers to bring safe products to market
Biocompatibility testing ensures that products on the market are not harming users they are in contact with. Virologica offers a series of in vitro methods that can provide this information while minimising, de-risking or replacing the need for animal testing and clinical trials.
Biocompatibility test methods
ISO 10993-5, OECD 439, ISO 10993-23, USP 87

Start The Conversation
Contact us today to explore how we can support you with your next project.